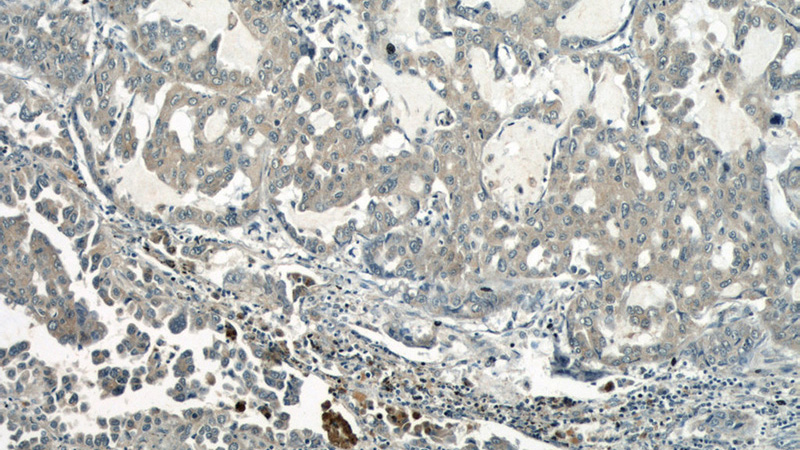
Immunohistochemical of paraffin-embedded human lung cancer using Catalog No:114777(RocK1 antibody) at dilution of 1:50 (under 10x lens)

-
Product Name
ROCK1 antibody
- Documents
-
Description
ROCK1 Rabbit Polyclonal antibody. Positive IHC detected in human lung cancer tissue, human tonsillitis tissue. Positive WB detected in HepG2 cells, A431 cells, HeLa cells, Jurkat cells, mouse spleen tissue, NIH/3T3 cells. Observed molecular weight by Western-blot: 150-160kd
-
Tested applications
ELISA, WB, IHC
-
Species reactivity
Human,Mouse,Rat; other species not tested.
-
Alternative names
p160 ROCK 1 antibody; P160ROCK antibody; PRO0435 antibody; ROCK1 antibody
-
Isotype
Rabbit IgG
-
Preparation
This antibody was obtained by immunization of R℃K1 recombinant protein (Accession Number: NM_005406). Purification method: Antigen affinity purified.
-
Clonality
Polyclonal
-
Formulation
PBS with 0.02% sodium azide and 50% glycerol pH 7.3.
-
Storage instructions
Store at -20℃. DO NOT ALIQUOT
-
Applications
Recommended Dilution:
WB: 1:500-1:5000
IHC: 1:20-1:200
-
Validations

HepG2 cells were subjected to SDS PAGE followed by western blot with Catalog No:114777(RocK1 antibody) at dilution of 1:1000
Immunohistochemical of paraffin-embedded human lung cancer using Catalog No:114777(RocK1 antibody) at dilution of 1:50 (under 10x lens)

Immunohistochemical of paraffin-embedded human lung cancer using Catalog No:114777(RocK1 antibody) at dilution of 1:50 (under 40x lens)
-
Background
RocK1, also named as p160RocK and NY-REN-35, belongs to the protein kinase superfamily and AGC Ser/Thr protein kinase family. RocK1 phosphorylates and activates DAPK3, which then regulates myosin light chain phosphatase through phosphorylation of MYPT1 thereby regulating the assembly of the actin cytoskeleton, cell migration, invasiveness of tumor cells, smooth muscle contraction and neurite outgrowth. RocK1 is required for centromere positioning and centromere-dependent exit from mitosis. It is necessary for apoptotic membrane blebbing. RocK1 catalyzes the reaction: ATP + a protein = ADP + a phosphoprotein.
-
References
- Wang J, Sun L, Yang M. DEK depletion negatively regulates Rho/ROCK/MLC pathway in non-small cell lung cancer. The journal of histochemistry and cytochemistry : official journal of the Histochemistry Society. 61(7):510-21. 2013.
- Gao Y, Song C, Hui L. Overexpression of RNF146 in non-small cell lung cancer enhances proliferation and invasion of tumors through the Wnt/β-catenin signaling pathway. PloS one. 9(1):e85377. 2014.
- Huang W, Liu J, Feng X. DLC-1 induces mitochondrial apoptosis and epithelial mesenchymal transition arrest in nasopharyngeal carcinoma by targeting EGFR/Akt/NF-κB pathway. Medical oncology (Northwood, London, England). 32(4):115. 2015.
- Chen K, He H, Xie Y. miR-125a-3p and miR-483-5p promote adipogenesis via suppressing the RhoA/ROCK1/ERK1/2 pathway in multiple symmetric lipomatosis. Scientific reports. 5:11909. 2015.
Related Products / Services
Please note: All products are "FOR RESEARCH USE ONLY AND ARE NOT INTENDED FOR DIAGNOSTIC OR THERAPEUTIC USE"
